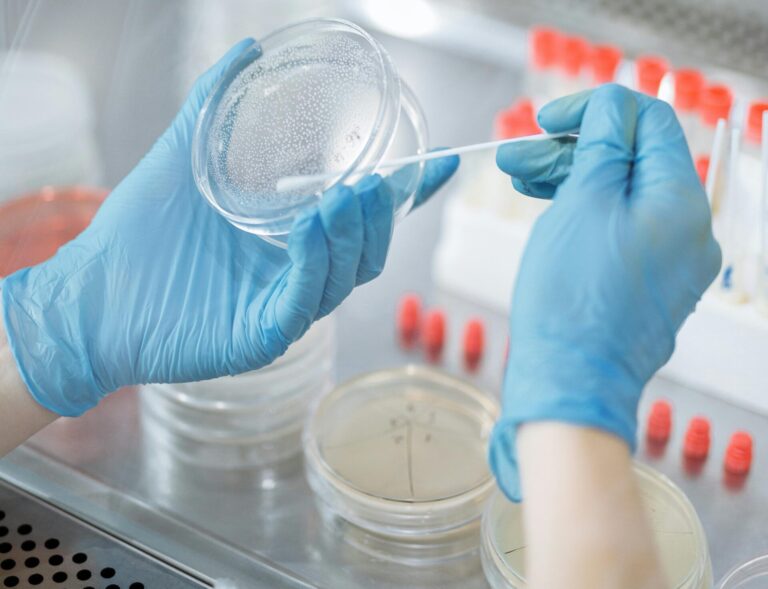

Delivering the Future of Health

A weekly newsletter bringing you the latest insights, breakthroughs, and news from the world of science & technology.

Breakthrough in Microbial Research
Microbial preservation refers to storing microorganisms in a way that slows down their metabolism and prevents them from dying or mutating over time. It is essential because it allows scientists to keep track of different types of microorganisms, compare them to other strains of microorganisms, and use them to develop new treatments for disease. BiomLife® offers several advantages:
- Zero proliferation of microbes
- Maintains viability
- Excellent integrity of DNA & RNA
- PCR and RT-PCR
- Sequencing
- Metagenomics, Proteomics, Metabolomics
- Functional genomics
Our nation’s brilliant scientists and researchers can use this product in diverse fields such as medical research, pathology, drug development, public health, and agriculture by preserving the microbiome in this buffer for further microbial studies. With BiomLife®, users can be assured that their sensitive biological samples will arrive at their destination in excellent condition, ready for analysis and experimentation. By embracing this product, researchers and healthcare providers worldwide can focus on delivering exceptional patient outcomes and driving scientific discovery forward.
Experience the research with BiomLife® and discover how it can make the world a better place every day. You can preserve and transport aerobic and anaerobic microbes (bacteria, fungi, viruses). Transform Your Microbial Studies with BiomLife®.
A universal transport medium for specimen collection, preservation & transportation. You can preserve and transport the samples from:

Website link in Bio!